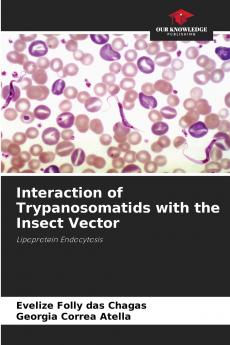
Interaction of Trypanosomatids with the Insect Vector

Paperback
₹4280
₹5626
23.92% OFF
(All inclusive*)
Delivery Options
Please enter pincode to check delivery time.
*COD & Shipping Charges may apply on certain items.
Review final details at checkout.
Looking to place a bulk order? SUBMIT DETAILS
Delivery Options
Please enter pincode to check delivery time.
*COD & Shipping Charges may apply on certain items.
Review final details at checkout.
About The Book
Description
Author(s)
In the Americas two species of trypanosomes have a high incidence and medical importance: Trypanosoma cruzi and Trypanosoma rangeli. These two parasites use invertebrate hosts members of the Reduviidae family especially Rhodnius prolixus. During its life cycle T. rangeli crosses the intestinal epithelium and invades the insect's hemolymph while T. cruzi remains in the lumen of the vector's intestine. In the present study we demonstrate for the first time the uptake of lipophorin (Lp) which is the main lipid transport particle in the insect's hemolymph by these trypanosomes.
Details
ISBN 13
9786202370394
Publication Date
-11-08-2025
Pages
-76
Weight
-116 grams
Dimensions
-152x229x4.62 mm